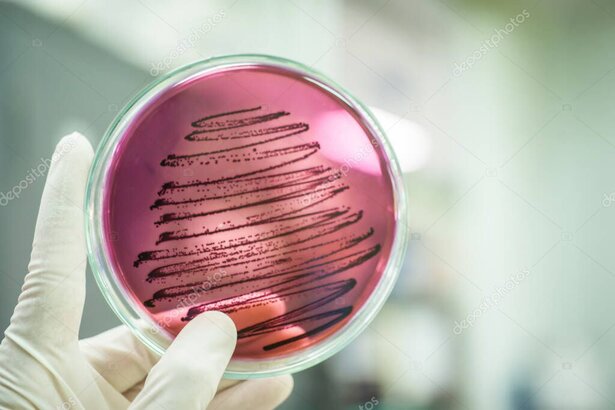
Effets spéciaux sécuritaires avec étincelles froides

Retour d’expérience sur un mandat complet: logistique, technique et résultats.
Normes, permis et trucs pour utiliser fumée et étincelles froides en toute sécurité.

Connexion, encodeurs, caméras et audio: ce qu’il faut préparer pour une diffusion fluide.

Différences, effets visuels et scénarios d’utilisation pour rehausser l’expérience.

Guide rapide pour estimer la puissance nécessaire en fonction de la capacité et de l’acoustique.

Liste de vérification prête à l’emploi pour activités scolaires: son, lumières, montage et sécurité.
